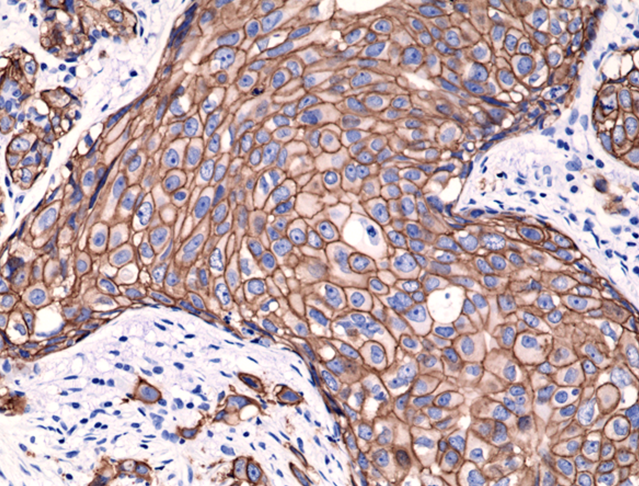

在抗击疾病的长路上,临床诊断的精准性是医者守护生命的基石。从肿瘤标志物检测到感染病原体筛查,高质量抗体试剂如同医者的“分子显微镜”,为诊疗决策提供关键支撑。
RevMab作为专注于肿瘤与免疫领域的抗体研发先锋,始终致力于为临床与科研工作者提供高特异性、高灵敏度的抗体工具原料,助力精准医疗的每一步突破。
我们无法做到完美,所以我评价一个人就看他在做不可能完成的事情时,失败得有多精彩。 ——威廉·福克纳
我们精选几款核心产品,致敬医者探索精神:
• 应用价值:雄激素受体剪接变异体AR-V7是去势抵抗性前列腺癌(CRPC)的 耐药标志物。其表达提示阿比特龙/恩杂鲁胺等内分泌治疗失效,需及早切换化疗或新型靶向治疗。
• 技术优势:
✓ 突变特异性识别:精准捕获AR-V7蛋白,与野生型AR零交叉(假阳性率<0.1%);
✓ 微转移灶洞察:对循环肿瘤细胞(CTC)中低丰度表达仍可检出,实现液体活检突破;
✓ 用药决策导航。
使用抗 AR-V7兔单克隆抗体(克隆 RM7)对福尔马林固定和石蜡包埋骨转移前列腺癌的免疫组化染色。经临床验证 ARv7 呈阳性。图片由美国华盛顿大学的Stephen Plymate 博士提供。
• 应用价值:人表皮生长因子受体2是乳腺癌、胃癌等实体瘤的核心驱动基因,其扩增或过表达提示肿瘤侵袭性强、预后差。据统计,乳腺癌中HER2阳性率约15-20%,胃癌中约20%,且与靶向药物疗效直接关联,其检测结果直接决定曲妥珠单抗、ADC药物等治疗方案的选择,影响患者生存期。
• 技术优势:
✓ 可识别185kDa全长糖基化HER2及截短突变体,避免漏诊;
✓ 高特异性结合HER2受体,与EGFR、HER3等受体零交叉反应,确保结果特异性;
✓ 对福尔马林固定组织表位回收率>95%,解决降解样本假阴性难题。
使用抗 HER2兔单克隆抗体(克隆 RM228)对福尔马林固定和石蜡包埋的人乳腺癌组织进行免疫组织化学染色。
•应用价值:IDH1 R132H突变是Ⅱ-Ⅲ级星形细胞瘤的黄金诊断标志物,阳性患者生存期显著延长,直接影响手术范围与放化疗策略。
•技术优势:
✓ 位点专一性:仅靶向R132H突变,无视野生型IDH1干扰;
✓ 历史样本唤醒:对福尔马林固定10年以上组织检出率>90%。

使用抗 IDH1(R132H) 兔单克隆抗体(克隆 RM390)对福尔马林固定和石蜡包埋的人胶质母细胞瘤进行免疫组织化学染色。
我们无法做到完美,所以我评价一个人就看他在做不可能完成的事情时,失败得有多精彩。 ——威廉·福克纳
医学的进步,始于人类对生命的渴望,成于医者与科研者的接力探索。
RevMAb将持续深耕肿瘤微环境抗体开发与伴随诊断试剂原料优化,与医者并肩同行,因为我们深知,每一份精准的检测报告背后,都是患者重获新生的希望;每一篇研究的突破,都在为人类健康增添一道防线!
有时是治愈;常常是帮助;总是去安慰。
----特鲁多医生
“医者须负医者心,用生命坚守誓言”。在这个属于医师的节日里,RevMAb愿以科技之力,成为医者手中的“分子手术刀”,共赴一场守护生命的远征。
致敬所有白衣战士
愿你们坚守的信念,终将照亮人类健康的星河长明。
RevMab与您同行,让精准诊疗惠及万千生命。
Post time: 2025-08-16 17:44:04
- Previous: 幽门螺杆菌检测,RevMAb多款兔单克隆抗体,解决检测核心痛点。
- Next: 中性粒细胞活性,arigoPLEX® 检测快又准
